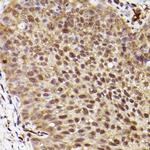
ERK1 Antibody in Immunohistochemistry (Paraffin) (IHC (P))

Search
Invitrogen
ERK1 Recombinant Rabbit Monoclonal Antibody (0B0C1)
{{$productOrderCtrl.translations['antibody.pdp.commerceCard.promotion.promotions']}}
{{$productOrderCtrl.translations['antibody.pdp.commerceCard.promotion.viewpromo']}}
{{$productOrderCtrl.translations['antibody.pdp.commerceCard.promotion.promocode']}}: {{promo.promoCode}} {{promo.promoTitle}} {{promo.promoDescription}}. {{$productOrderCtrl.translations['antibody.pdp.commerceCard.promotion.learnmore']}}
图: 1 / 6
ERK1 Antibody (MA5-42706) in IHC (P)

Please note: We are reviewing Western blot images included in the antibody testing data in our catalog, including those provided by third parties. Unless expressly labeled or annotated as “raw-unedited”, Western blot images included in the antibody testing data in our catalog may have been edited, optimized or otherwise adjusted for presentation.
产品信息
MA5-42706
种属反应
宿主/亚型
Expression System
分类
类型
克隆号
抗原
偶联物
形式
浓度
规格
纯化类型
保存液
内含物
保存条件
运输条件
RRID
产品详细信息
Positive test controls include: Raji, HepG2, 293T, Jurkat, Mouse kidney, Mouse heart, Rat brain, Rat lung. The target is usually found in the following locations: Cytoplasm, Nucleus.
Immunogen sequence: MAAAAAQGGG GGEPRRTEGV GPGVPGEVEM VKGQPFDVGP RYTQLQYIGE GAYGMVSSAY DHVRKTRVAI KKISPFEHQT YCQRTLREIQ ILLRFRHENV
靶标信息
MAPK3 (ERK1) is a serine/threonine kinase that is an important activator of p90, RSK, MSK, ELK1, and Stat3, and is involved in the MAPK pathway. ERK1 is widely expressed and involved in the regulation of meiosis, mitosis, and post-mitotic functions in differentiated cells. Many different stimuli, including growth factors, cytokines, virus infection, ligands for heterotrimeric guanine nucleotide-binding protein (G protein)-coupled receptors and transforming agents, activate the ERK1 and ERK2 pathways. Functionally, ERK1 is involved with a signaling cascade that regulates various cellular processes such as proliferation, differentiation, and cell cycle progression in response to a variety of extracellular signals. ERK1 is activated by upstream kinases, resulting in its translocation to the nucleus where it phosphorylates nuclear targets. Alternatively spliced transcript variants encoding different protein isoforms of ERK1 have been described.
仅用于科研。不用于诊断过程。未经明确授权不得转售。
篇参考文献 (0)
生物信息学
蛋白别名: ERK; ERK-1; ERT2; Extracellular signal-regulated kinase 1; Insulin-stimulated MAP2 kinase; MAP kinase 3; MAP kinase isoform p44; MAP kinase2; MAPK2; Microtubule-associated protein 2 kinase; Mitogen-activated protein kinase 3; MNK1; p44 MAP kinase; p44-ERK1; p44-MAPK; pp42/MAP kinase
基因别名: Erk-1; ERK1; Ert2; Esrk1; MAPK3; Mnk1; Mtap2k; p44; p44erk1; p44mapk; PRKM3
UniProt ID: (Mouse) Q63844
Entrez Gene ID: (Mouse) 26417




